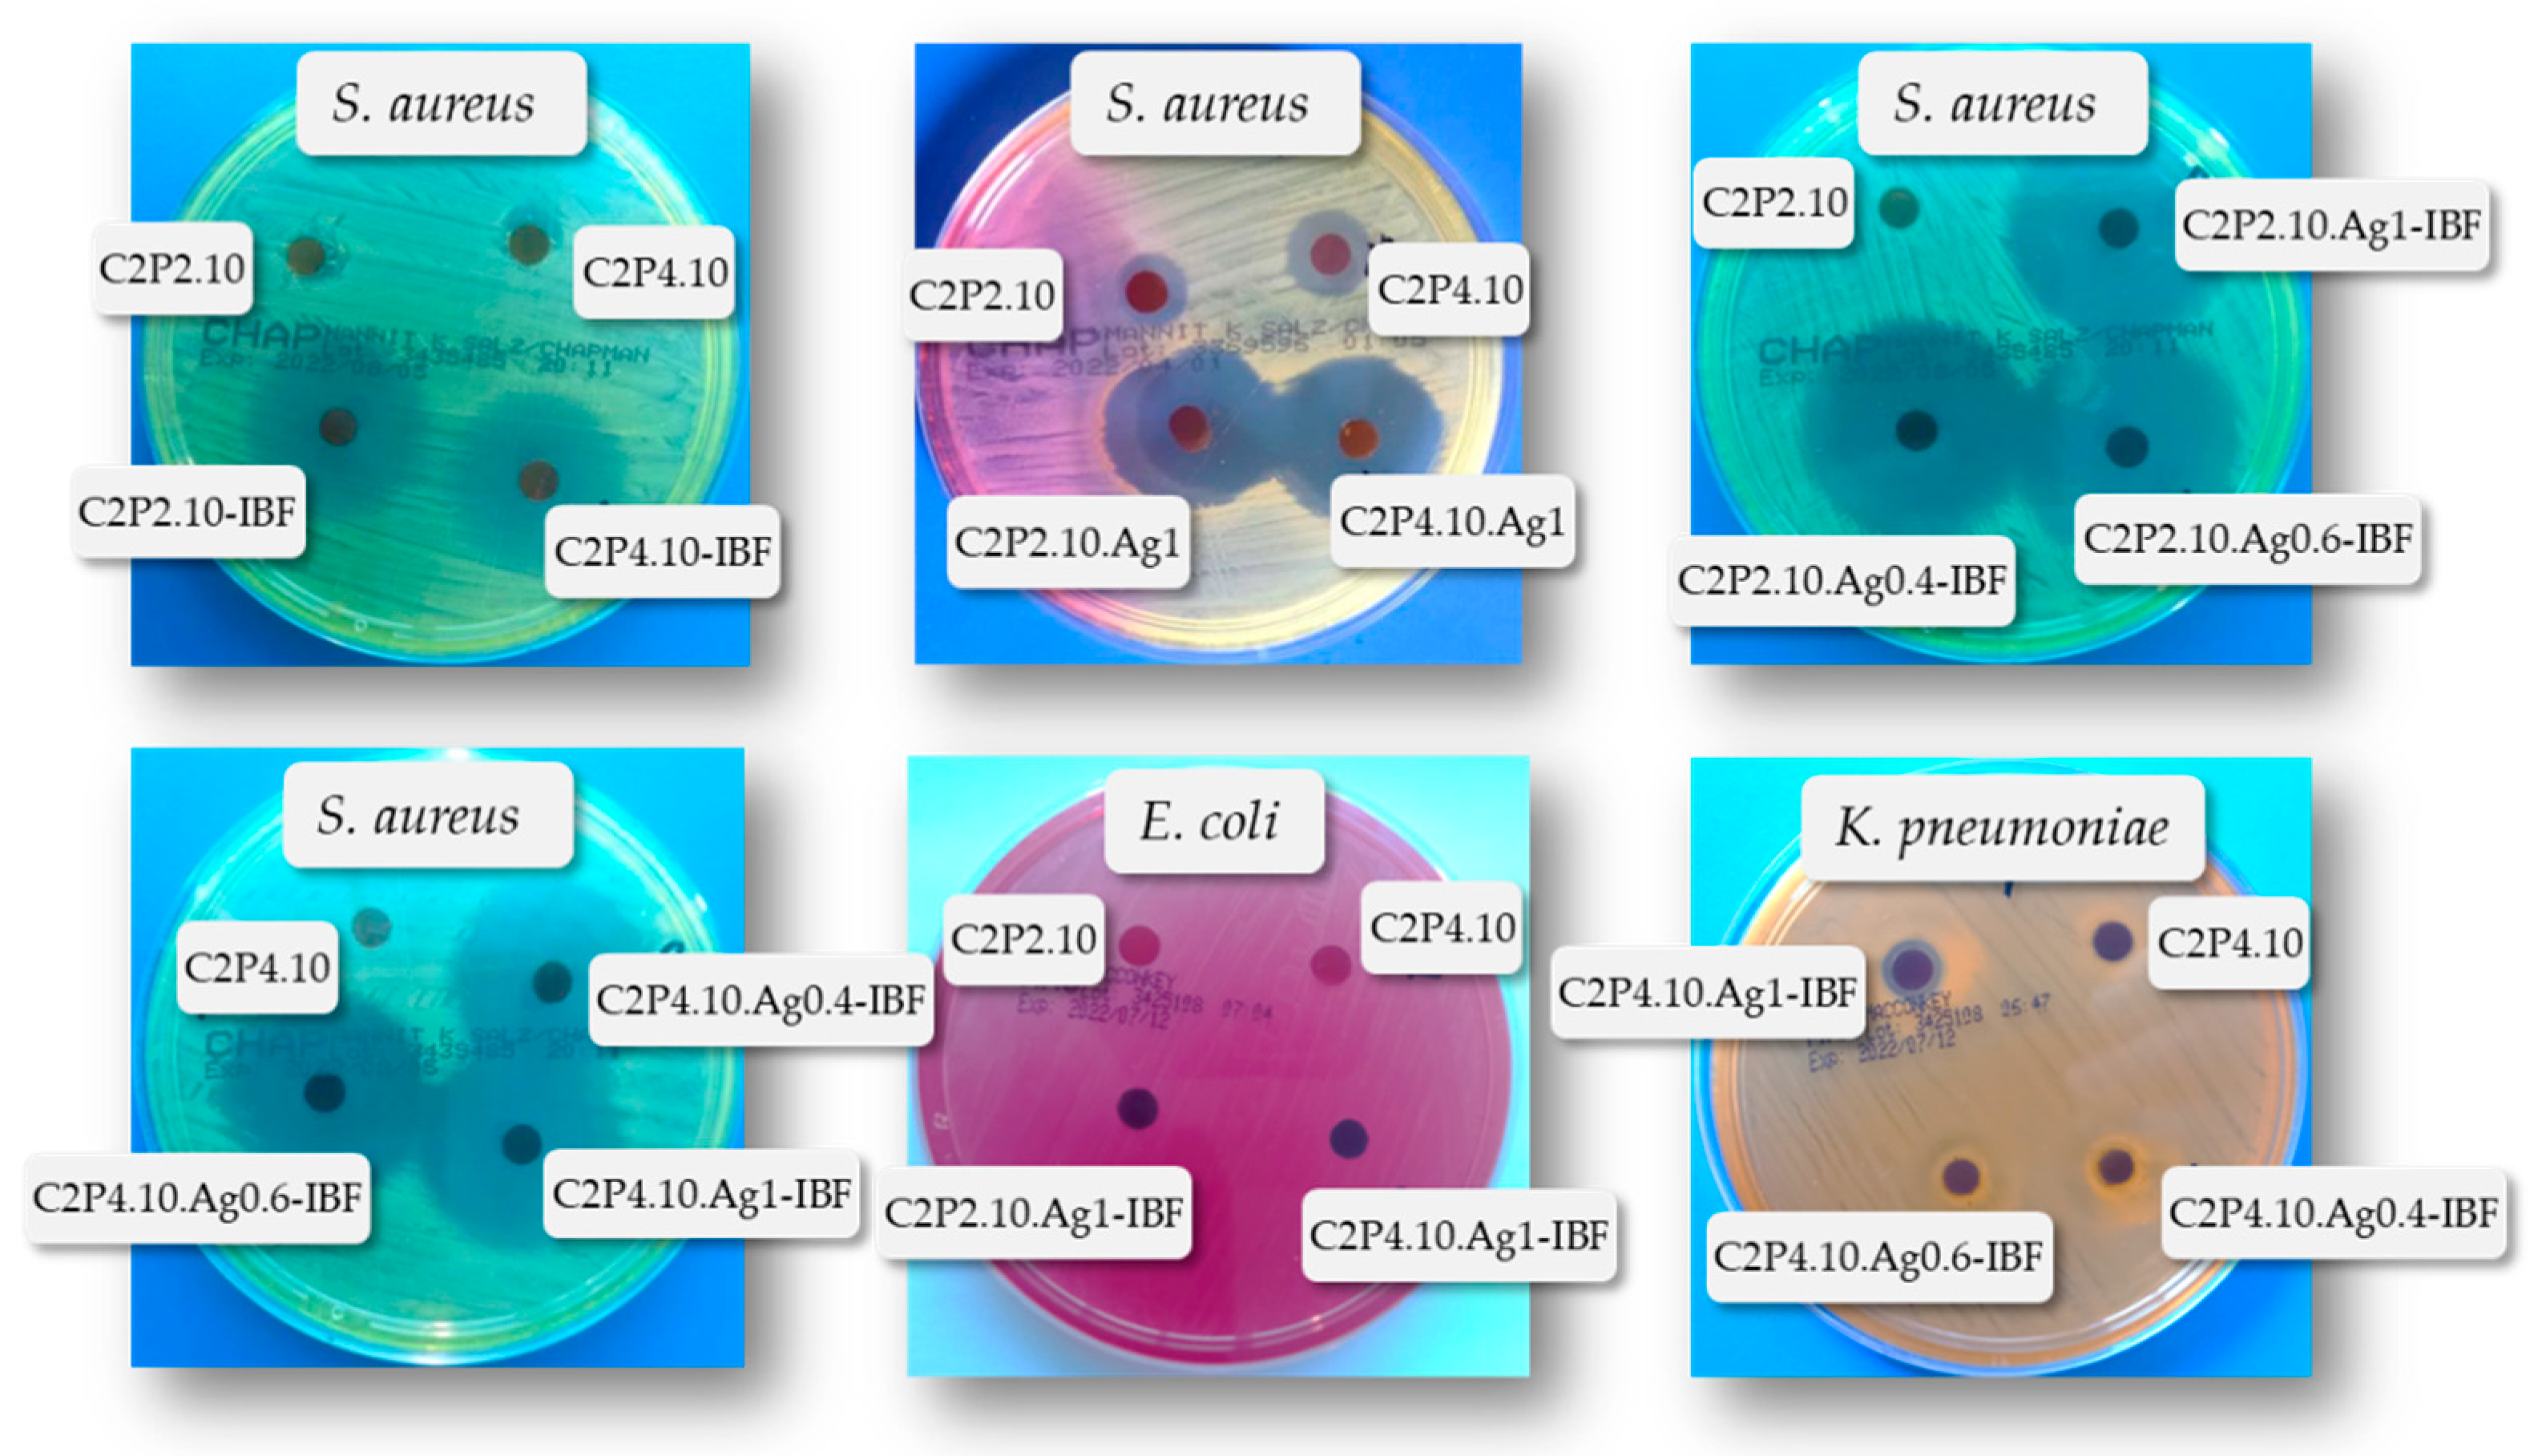
Ijms 23 10671 g011

Silver Nanoparticles Biocomposite Films with Antimicrobial Activity: In Vitro and In Vivo Tests
Abstract
1. Introduction
2. Results and Discussion
2.1. Characterization of the Obtained AgNps
2.2. Structural Characteristics of Films
2.3. Morphological Characteristics
2.4. Mechanical Properties of Films
2.5. Swelling Capacity of Films in Aqueous Solution
2.6. Films Loaded with IBF
2.7. In Vitro Release of IBF
2.8. The In Vitro Cytotoxic Effects
2.9. Evaluation of Antimicrobial Activity
2.10. In Vivo Tests
3. Materials and Methods
3.1. Materials
3.2. The AgNps Preparation Method
3.3. The Films Preparation Method
3.4. Characterization of the Obtained AgNps
3.5. Characterization of the Obtained Films
3.5.1. The Structural Characteristics
3.5.2. The Morphological Characteristics
3.5.3. Mechanical Properties of Films
3.5.4. Swelling Capacity of Films in Aqueous Solution
3.5.5. Films Loaded with IBF
3.5.6. In Vitro Release of IBF
3.5.7. The In Vitro Cytotoxic Effects
3.5.8. Evaluation of Antimicrobial Activity
3.5.9. In Vivo Tests
Supplementary Materials
Author Contributions
Funding
Institutional Review Board Statement
Informed Consent Statement
Data Availability Statement
Conflicts of Interest
References
- Shuqiang, L.; Shujun, D.; Weiguo, X.; Shicheng, T.; Lesan, Y.; Changwen, Z.; Jianxun, D.; Xuesi, C. Antibacterial Hydrogels. Adv. Sci. 2018, 5, 1700527. [Google Scholar]
- Kim, H.S.; Sun, X.; Lee, J.H.; Kim, H.W.; Fu, X.; Leong, K.W. Advanced drug delivery systems and artificial skin grafts for skin wound healing. Adv. Drug Deliv. Rev. 2018, 146, 209–239. [Google Scholar] [CrossRef] [PubMed]
- Zhang, S.; Ou, Q.; Xin, P.; Yuan, Q.J.; Wang, Y.; Wu, J. Polydopamine/Puerarin nanoparticles incorporated hybrid hydrogels for enhanced wound healing. Biomater. Sci. 2019, 7, 4230–4236. [Google Scholar] [CrossRef] [PubMed]
- Abdulkhani, A.; Echresh, Z.; Allahdadi, M. Effect of nanofibers on the structure and properties of biocomposites. Micro Nano Technol. 2020, 321–357. [Google Scholar] [CrossRef]
- Raheja, I.; Kohli, K.; Drabu, S. Periodontal drug delivery system containing antimicrobial agents. Int. J. Pharm. Pharm. Sci. 2013, 5, 11–16. [Google Scholar]
- Cao, Z.; Luo, Y.; Li, Z.; Tan, L.; Liu, X.; Li, C.; Zheng, Y.; Cui, Z.; Yeung, K.W.K.; Liang, Y.; et al. Antibacterial Hybrid Hydrogels. Macromol. Biosci. 2020, 21, 2000252. [Google Scholar] [CrossRef]
- Palmese, L.L.; Thapa, R.K.; Sullivan, M.O.; Kiick, K.L. Hybrid hydrogels for biomedical applications. Curr. Opin. Chem. Eng. 2019, 24, 143–157. [Google Scholar] [CrossRef]
- Stojkovska, J.; Djurdjevic, Z.; Jancic, I.; Bufan, B.; Milenkovic, M.; Jankovic, R.; Miskovic-Stankovic, V.; Obradovic, B. Comparative in vivo evaluation of novel formulations based on alginate and silver nanoparticles for wound treatments. J. Biomater. Appl. 2018, 32, 1197–11211. [Google Scholar] [CrossRef]
- Lin, Y.H.; Hsu, W.S.; Chung, W.Y.; Ko, T.H.; Lin, J.H. Evaluation of various silver-containing dressing on infected excision wound healing study. J. Mater. Sci. Mater. Med. 2014, 25, 1375–1386. [Google Scholar] [CrossRef]
- Pangli, H.; Vatanpour, S.; Hortamani, S.; Jalili, R.; Ghahary, A. Incorporation of Silver Nanoparticles in Hydrogel Matrices for Controlling Wound Infection. J. Burn. Care. Res. 2021, 42, 785–793. [Google Scholar] [CrossRef]
- Zhang, X.F.; Liu, Z.G.; Shen, W.; Gurunathan, S. Silver nanoparticles: Synthesis, characterization, properties, applications, and therapeutic approaches. Int. J. Mol. Sci. 2016, 17, 1534. [Google Scholar] [CrossRef] [PubMed]
- Mohanty, S.; Mishra, S.; Jena, P.; Jacob, B.; Sarkar, B.; Sonawane, A. An investigation on the antibacterial, cytotoxic, and antibiofilm efficacy of starch-stabilized silver nanoparticles. Nanomedicine 2012, 8, 916–924. [Google Scholar] [CrossRef] [PubMed]
- Rai, M.K.; Deshmukh, S.D.; Ingle, A.P.; Gade, A.K. Silver nanoparticles: The powerful nanoweapon against multidrug-resistant bacteria. J. Appl. Microbiol. 2012, 112, 841–852. [Google Scholar] [CrossRef] [PubMed]
- Riaz Ahmed, K.B.; Nagy, A.M.; Brown, R.P.; Zhang, Q.; Malghan, S.G.; Goering, P.L. Silver nanoparticles: Significance of physicochemical properties and assay interference on the interpretation of in vitro cytotoxicity studies. Toxicol. In Vitro 2017, 38, 179–192. [Google Scholar] [CrossRef] [PubMed]
- Durán, N.; Durán, M.; de Jesus, M.B.; Seabra, A.B.; Fávaro, W.J.; Nakazato, G. Silver nanoparticles: A new view on mechanistic aspects on antimicrobial activity. Nanomedicine 2016, 12, 789–799. [Google Scholar] [CrossRef] [PubMed]
- Zucker, R.M.; Ortenzio, J.; Degn, L.L.; Lerner, J.M.; Boyes, W.K. Biophysical comparison of four silver nanoparticles coatings using microscopy, hyperspectral imaging and flow cytometry. PLoS ONE 2019, 14, e0219078. [Google Scholar] [CrossRef] [PubMed]
- Li, J.; Rong, K.; Zhao, H.; Li, F.; Lu, Z.; Chen, R. Highly selective antibacterial activities of silver nanoparticles against Bacillus subtilis. J. Nanosci. Nanotechnol. 2013, 13, 6806–6813. [Google Scholar] [CrossRef]
- Kim, J.S.; Kuk, E.; Yu, K.N.; Kim, J.H.; Park, S.J.; Lee, H.J.; Kim, S.H.; Park, Y.K.; Park, Y.H.; Hwang, C.Y.; et al. Antimicrobial effects of silver nanoparticles. Nanomedicine 2007, 3, 95–101. [Google Scholar] [CrossRef]
- Wu, D.; Fan, W.; Kishen, A.; Gutmann, J.L.; Fan, B. Evaluation of the antibacterial efficacy of silver nanoparticles against Enterococcus faecalis biofilm. J. Endodontics 2014, 40, 285–290. [Google Scholar] [CrossRef]
- Radzig, M.A.; Nadtochenko, V.A.; Koksharova, O.A.; Kiwi, J.; Lipasova, V.A.; Khmel, I.A. Antibacterial effects of silver nanoparticles on gram-negative bacteria: Influence on the growth and biofilms formation, mechanisms of action. Colloids Surf. B Biointerfaces 2013, 102, 300–306. [Google Scholar] [CrossRef]
- Ansari, M.A.; Khan, H.M.; Khan, A.A.; Cameotra, S.S.; Alzohairy, M.A. Anti-biofilm efficacy of silver nanoparticles against MRSA and MRSE isolated from wounds in a tertiary care hospital. Indian J. Med. Microbiol. 2015, 33, 101–109. [Google Scholar] [CrossRef] [PubMed]
- Gurunathan, S.; Han, J.W.; Kwon, D.N.; Kim, J.H. Enhanced antibacterial and anti-biofilm activities of silver nanoparticles against Gram-negative and Gram-positive bacteria. Nanoscale Res. Lett. 2014, 9, 373. [Google Scholar] [CrossRef] [PubMed]
- Cheon, J.Y.; Kim, S.J.; Rhee, Y.H.; Kwon, O.H.; Park, W.H. Shape-dependent antimicrobial activities of silver nanoparticles. Int. J. Nanomed. 2019, 14, 2773–2780. [Google Scholar] [CrossRef] [PubMed]
- Saqib, S.; Zaman, W.; Ayaz, A.; Habib, S.; Bahadur, S.; Hussain, S.; Muhammad, S.; Ullah, F. Postharvest disease inhibition in fruit by synthesis and characterization of chitosan iron oxide nanoparticles. Biocat. Agric. Biotechnol. 2020, 28, 101729. [Google Scholar] [CrossRef]
- Saqib, S.; Nazeer, A.; Ali, M.; Zaman, W.; Younas, M.; Shahzad, A.; Nisar, S.M. Catalytic potential of endophytes facilitates synthesis of biometallic zinc oxide nanoparticles for agricultural application. BioMetals 2022, 2022, 1–9. [Google Scholar] [CrossRef]
- Gherasim, O.; Puiu, R.A.; Bîrcă, A.C.; Burdușel, A.C.; Grumezescu, A.M. An Updated Review on Silver Nanoparticles in Biomedicine. Nanomaterials 2020, 10, 2318. [Google Scholar] [CrossRef]
- Gurunathan, S.; Qasim, M.; Park, C.; Yoo, H.; Choi, D.; Song, H.; Park, C.; Kim, J.H.; Hong, K. Cytotoxicity and Transcriptomic Analysis of Silver Nanoparticles in Mouse Embryonic Fibroblast Cells. Int. J. Molec. Sci. 2018, 19, 3618. [Google Scholar] [CrossRef]
- Paknejadi, M.; Bayat, M.; Salimi, M.; Razavilar, V. Concentration- and Time-Dependent Cytotoxicity of Silver Nanoparticles on Normal Human Skin Fibroblast Cell Line, Iran. Red. Crescent. Med. J. 2018, 20, 1–8. [Google Scholar] [CrossRef]
- Mohan, N.; Mohanan, P.V.; Sabareeswaran, A.; Nair, P. Chitosan-hyaluronic acid hydrogel for cartilage repair. Int. J. Boil. Macromol. 2017, 104, 1936–1945. [Google Scholar] [CrossRef]
- Kumar, A.; Han, S.S. PVA-based hydrogels for tissue enginering: A review. Int. J. Polym. Mater. 2016, 66, 159–182. [Google Scholar] [CrossRef]
- Popescu, I.; Constantin, M.; Pelin, I.M.; Suflet, D.M.; Ichim, D.L.; Daraba, O.M.; Fundueanu, G. Eco-Friendly Synthesized PVA/Chitosan/Oxalic Acid Nanocomposite Hydrogels Embedding Silver Nanoparticles as Antibacterial Materials. Gels 2022, 8, 268. [Google Scholar] [CrossRef] [PubMed]
- Kamoun, E.A.; Chen, X.; Mohy Eldin, M.S.; Kenawy, E.-R.S. Crosslinked poly(vinyl alcohol) hydrogels for wound dressing applications: A review of remarkably blended polymers. Arab. J. Chem. 2015, 8, 1–14. [Google Scholar] [CrossRef]
- Sze Huei, G.O.; Muniyandy, S.; Sathasivam, T.; Veeramachineni, A.K.; Janarthanan, P. Iron cross-linked carboxymethyl cellulose–gelatin complex coacervate beads for sustained drug delivery. Chem. Papers 2016, 70, 243–252. [Google Scholar] [CrossRef]
- Parker, N.; Schneegurt, M.; Thi Tu, A.H.; Forster, B.M.; Lister, P. Chapter 9: Microbial Growth. In Microbiology; ASM Press: Washington, DC, USA; OpenStax: Houston, TX, USA, 2016; pp. 330–367. [Google Scholar]
- Mosmann, T. Rapid colorimetric assay for cellular growth and survival: Application to proliferation and cytotoxicity assays. J. Immunol. Methods 1983, 65, 55–63. [Google Scholar] [CrossRef]
- López-García, J.; Lehocký, M.; Humpolíček, P.; Sáha, P. HaCaT Keratinocytes Response on Antimicrobial Atelocollagen Substrates: Extent of Cytotoxicity, Cell Viability and Proliferation. J. Funct. Biomater. 2014, 5, 43–57. [Google Scholar] [CrossRef] [PubMed]
- Balouiri, M.; Sadiki, M.; Ibnsouda, S.K. Methods for in vitro evaluating antimicrobial activity: A review. J. Pharm. Anal. 2016, 6, 71–79. [Google Scholar] [CrossRef]
- Rata, D.M.; Cadinoiu, A.N.; Popa, M.; Atanase, L.I.; Daraba, O.M.; Popescu, I.; Romila, L.E.; Ichim, D.L. Biocomposite Hydrogels for the Treatment of Bacterial Infections: Physicochemical Characterization and In Vitro Assessment. Pharmaceutics 2021, 13, 2079. [Google Scholar] [CrossRef]
- Yan, D.; Li, Y.; Liu, Y.; Li, N.; Zhang, X.; Yan, C. Antimicrobial Properties of Chitosan and Chitosan Derivatives in the Treatment of Enteric Infections. Molecules 2021, 26, 7136. [Google Scholar] [CrossRef]
- Suflet, D.M.; Popescu, I.; Pelin, I.M.; Ichim, D.L.; Daraba, O.M.; Constantin, M.; Fundueanu, G. Dual Cross-Linked Chitosan/PVA Hydrogels Containing Silver Nanoparticles with Antimicrobial Properties. Pharmaceutics 2021, 13, 1461. [Google Scholar] [CrossRef]
- Rigal, C.; Pieraggi, M.T.; Vincent, C.; Prost, C.; Bouissou, H.; Serre, G. Healing of fullthickness cutaneous wounds in the pig. I. Immunohistochemical study of epidermo-dermal junction regeneration. J. Investig. Dermatol. 1991, 96, 777–785. [Google Scholar] [CrossRef]
- Rousselle, P.; Beck, K. Laminin 332 processing impacts cellular behavior. Cell Adhes. Migr. 2013, 7, 122–134. [Google Scholar] [CrossRef] [PubMed]
- Stanley, J.R.; Alvarez, O.M.; Bere, E.W.; Eaglstein, W.H.; Katz, S.I. Detection of basement membrane zone antigens during epidermal wound healing in pigs. J. Investig. Dermatol. 1981, 77, 240–243. [Google Scholar] [CrossRef] [PubMed]
- Demarchez, M.; Desbas, C.; Prunieras, M. Wound healing of human skin transplanted onto the nude mouse. II. An immunohistological and ultrastructural study of the epidermal basement membrane zone reconstruction and connective tissue reorganization. Dev. Biol. 1987, 121, 119–129. [Google Scholar] [PubMed]
- Demarchez, M.; Sengel, P.; Prunieras, M. Wound healing of human skin transplanted onto the nude mouse. I. An immunohistological study of the reepithelialization process. Dev. Biol. 1986, 113, 90–96. [Google Scholar] [CrossRef]
- Odland, G.; Ross, R. Human wound repair. I. Epidermal regeneration. J. Cell Biol. 1968, 39, 135–151. [Google Scholar] [CrossRef]
- Mansbridge, J.N.; Knapp, A.M. Changes in keratinocyte maturation during wound healing. J. Investig. Dermatol. 1987, 89, 253–263. [Google Scholar] [CrossRef]
- Barrientos, S.; Stojadinovic, O.; Golinko, M.S.; Brem, H.; Tomic-Canic, M. Growth factors and cytokines in wound healing. Wound Repair Regen. 2008, 16, 585–601. [Google Scholar] [CrossRef]
- Carter, W.G.; Ryan, M.C.; Gahr, P.J. Epiligrin, a new cell adhesion ligand for integrin α3β1 in epithelial basement membranes. Cell 1991, 65, 599–610. [Google Scholar] [CrossRef]
- Hamill, K.J.; McLean, W.H. The alpha-3 polypeptide chain of laminin 5: Insight into wound healing responses from the study of genodermatoses. Clin. Exp. Dermatol. 2005, 30, 398–404. [Google Scholar] [CrossRef]
- Coulombe, P.A. Wound epithelialization: Accelerating the pace of discovery. J. Investig. Dermatol. 2003, 121, 219–230. [Google Scholar] [CrossRef]
- Freedberg, I.M.; Tomic-Canic, M.; Komine, M.; Blumenberg, M. Keratins and the keratinocyte activation cycle. J. Investig. Dermatol. 2001, 116, 633–640. [Google Scholar] [CrossRef] [PubMed]
- Wong, P.; Coulombe, P.A. Loss of keratin 6 (K6) proteins reveals a function for intermediate filaments during wound repair. J. Cell Biol. 2003, 163, 327–337. [Google Scholar] [CrossRef] [PubMed]
- Coulombe, P.A. Towards amolecular definition of keratinocyte activation after acute injury to stratified epithelia. Biochem. Biophys. Res. Commun. 1997, 236, 231–238. [Google Scholar] [CrossRef] [PubMed]
- Nickoloff, B.J.; Turka, L.A. Keratinocytes key immunocytes of the integument. Am. J. Pathol. 1993, 143, 325–331. [Google Scholar]
- Jiang, C.K.; Flanagan, S.; Ohtsuki, M.; Shuai, K.; Freedberg, I.M.; Blumenberg, M. Disease- activated transcription factor: Allergic reactions in human skin cause nuclear transcription of STAT-91 and induce synthesis of keratin K17. Mol. Cell Biol. 1994, 14, 4759–4769. [Google Scholar]
- Michopoulou, A.; Rousselle, P. How do epidermal matrix metalloproteinases support re-epithelialization during skin healing? Eur. J. Dermatol. 2015, 25, 33–42. [Google Scholar] [CrossRef]
- Walter, M.N.M.; Wright, K.T.; Fuller, H.R.; MacNeil, S.; Johnson, W.E.B. Mesenchymal stem cell-conditioned medium accelerates skin wound healing: An in vitro study of fibroblast and keratinocyte scratch assays. Exp. Cell Res. 2010, 316, 1271–1281. [Google Scholar] [CrossRef]
- Pastar, I.; Stojadinovic, O.; Yin, N.C.; Ramirez, H.; Nusbaum, A.G.; Sawaya, A.; Patel, S.B.; Khalid, L.; Isseroff, R.R.; Tomic-Canic, M. Epithelialization in wound healing: A comprehensive review. Adv. Wound Care 2014, 3, 445–464. [Google Scholar] [CrossRef]
- Purba, T.S.; Haslam, I.S.; Poblet, E.; Jiménez, F.; Gandarillas, A.; Izeta, A.; Paus, R. Human epithelial hair follicle stem cells and their progeny: Current state of knowledge, the widening gap in translational research and future challenges. BioEssays 2014, 36, 513–525. [Google Scholar] [CrossRef]
- Karakaya, S.; Süntar, I.; Yakinci, O.F.; Sytar, O.; Ceribasi, S.; Dursunoglu, B.; Ozbeka, H.; Guvenalpa, Z. In vivo bioactivity assessment on Epilobium species: A particular focus on Epilobium angustifolium and its components on enzymes connected with the healing process. J. Ethnopharmacol. 2020, 262, 113207. [Google Scholar] [CrossRef]
- Sato, T.; Kirimura, Y.; Mori, Y. The co-culture of dermal fibroblasts with human epidermal keratinocytes induces increased prostaglandin E2 production and cyclooxygenase 2 activity in fibroblasts. J. Investig. Dermatol. 1997, 109, 334–339. [Google Scholar] [CrossRef] [PubMed]
- Garlick, J.A.; Taichman, L.B. Fate of human keratinocyte during reepithelialization in an organotypic culture model. Lab. Investig. 1994, 70, 916–924. [Google Scholar] [PubMed]
- Müller-Decker, K.; Kopp-Schneider, A.; Marks, F.; Seibert, K.; Fürstenberger, G. Localization of prostaglandin H synthase isoenzymes in murine epidermal tumors. Mol. Carcinog. 1998, 23, 36–44. [Google Scholar] [CrossRef]
- Black, A.P.B.; Ardern-Jones, M.R.; Kasprowicz, V.; Bowness, P.; Jones, L.; Bailey, A.S.; Ogg, G.S. Human Keratinocyte Induction of Rapid Effector Function in Antigen-Specific Memory CD4+ and CD8+ T Cells. Eur. J. Immunol. 2007, 37, 1485–1493. [Google Scholar] [CrossRef]
- Tamoutounour, S.; Han, S.J.; Deckers, J.; Constantinides, M.G.; Hurabielle, C.; Harrison, O.J.; Bouladoux, N.; Linehan, J.L.; Link, V.M.; Vujkovic-Cvijin, I.; et al. Keratinocyte-Intrinsic MHCII Expression Controls Microbiota-Induced Th1 Cell Responses. Proc. Natl. Acad. Sci. USA 2019, 116, 23643–23652. [Google Scholar] [CrossRef]
- Griffiths, C.E.; Nickoloff, B.J. Keratinocyte Intercellular Adhesion Molecule-1 (ICAM-1) Expression Precedes Dermal T Lymphocytic Infiltration in Allergic Contact Dermatitis (Rhus Dermatitis). Am. J. Pathol. 1989, 135, 1045–1053. [Google Scholar]
- Du, W.J.; Reppel, L.; Leger, L.; Schenowitz, C.; Huselstein, C.; Bensoussan, D.; Carosella, E.D.; Han, Z.-C.; Rouas-Freiss, N. Mesenchymal Stem Cells Derived from Human Bone Marrow and Adipose Tissue Maintain Their Immunosuppressive Properties After Chondrogenic Differentiation: Role of HLA-G. Stem Cells Dev. 2016, 25, 1454–1469. [Google Scholar] [CrossRef]
- Kopecki, Z.; Luchetti, M.M.; Adams, D.H.; Strudwick, X.; Mantamadiotis, T.; Stoppacciaro, A.; Gabrielli, A.; Ramsay, R.G.; Cowin, A.J. Collagen loss and impaired wound healing is associated with c-Myb deficiency. J. Pathol. 2007, 211, 351–361. [Google Scholar] [CrossRef]
- Von der Mark, K.; Seibel, M.J.; Robins, S.P. Structure, biosynthesis and gene regulation of collagens in cartilage and bone. Dynamics of bone and cartilage metabolism. In Dynamics of Bone and Cartilage Metabolism: Principles and Clinical Applications, 2nd ed.; Academic Press: Cambridge, MA, USA, 2006; pp. 3–40. [Google Scholar]
- Baraniak, P.R.; McDevitt, T.C. Stem cell paracrine actions and tissue regeneration. Regen Med. 2010, 5, 121–143. [Google Scholar] [CrossRef]
- Zhang, C.; Kallakury, B.V.; Ross, J.S.; Mewani, R.R.; Sheehan, C.E.; Sakabe, I.; Luta, G.; Kumar, D.; Yadavalli, S.; Starr, J.; et al. The significance of TNFAIP8 in prostate cancer response to radiation and docetaxel and disease recurrence. Int. J. Cancer 2013, 133, 31–42. [Google Scholar] [CrossRef]
- Takahashi, Y.; Tsuruta, S.; Honda, A.; Fujiwara, Y.; Satoh, M.; Yasutake, A. Effect of dental amalgam on gene expression profiles in rat cerebrum, cerebellum, liver and kidney. J. Toxicol. Sci. 2012, 37, 663–666. [Google Scholar] [CrossRef] [PubMed][Green Version]
- Niture, S.; Ramalinga, M.; Kedir, H.; Patacsil, D.; Niture, S.S.; Li, J.; Mani, H.; Suy, S.; Collins, S.; Kumar, D. TNFAIP8 promotes prostate cancer cell survival by inducing autophagy. Oncotarget 2018, 9, 26884–26899. [Google Scholar] [CrossRef] [PubMed]
- Woodley, D.T.; Kim, Y.H. A double-blind comparison of adhesive bandages with the use of uniform suction blister wounds. Arch. Dermatol. 1992, 128, 1354–1357. [Google Scholar] [CrossRef]
- Eaglstein, W.H. Moist wound healing with occlusive dressings: A clinical focus. Dermatol. Surg. 2001, 2, 175–181. [Google Scholar] [CrossRef]
- Boateng, J.; Catanzano, O. Advanced therapeutic dressings for effective wound healing—A review. J. Pharm. Sci. 2015, 104, 3653–3680. [Google Scholar] [CrossRef]
- Demling, R.H.; Leslie DeSanti, M.D. The rate of re-epithelialization across meshed skin grafts is increased with exposure to silver. Burns 2002, 28, 264–266. [Google Scholar] [CrossRef]
- Ilenghoven, D.; Chan, C.Y.; Wan Ahmad Kamal, W.S.R.; MohdYussof, S.J.; Ibrahim, S. A review of wound dressing practices. Clin. Dermatol. J. 2017, 2, 133. [Google Scholar]
- Chattopadhyay, S.; Raines, R.T. Review collagen-based biomaterials for wound healing. Biopolymers 2014, 101, 821–833. [Google Scholar] [CrossRef]
- Doillon, C.J.; Silver, F.H. Collagen-based wound dressing: Effect of hyaluronic acid and fibronectin on wound healing. Biomaterials 1986, 7, 3–8. [Google Scholar] [CrossRef]
- Ishihara, M.; Nakanishi, K.; Ono, K.; Sato, M.; Kikuchi, M.; Saito, Y.; Yura, H.; Matsui, T.; Hattori, H.; Uenoyama, M.; et al. Photo crosslinkable chitosan as a dressing for wound occlusion and accelerator in healing process. Biomaterials 2002, 23, 833–840. [Google Scholar] [CrossRef]
- Cadinoiu, A.N.; Rata, D.M.; Atanase, L.I.; Daraba, O.M.; Gherghel, D.; Vochita, G.; Popa, M. Aptamer-Functionalized Liposomes as a Potential Treatment for Basal Cell Carcinoma. Polymers 2019, 11, 1515. [Google Scholar] [CrossRef] [PubMed]
- Hudzicki, J. Kirby-Bauer Disk Diffusion Susceptibility Test Protocol. American Society for Microbiology, 2009. Available online: https://asm.org/Protocols/Kirby-Bauer-Disk-Diffusion-Susceptibility-Test-Pro (accessed on 15 July 2022).

| Sample Code | The Amount of IBF Loaded in Films (g IBF/g Film) |
|---|---|
| C2P2.10-IBF | 0.063 |
| C2P2.10.Ag 1-IBF | 0.057 |
| C2P4.10-IBF | 0.061 |
| C2P4.10.Ag1-IBF | 0.059 |
| Sample Code | CS/PVA Ratio (mg/mg) | Moles of GA/Moles of Free NH2 and OH | Moles of MgSO4/Moles of Free NH2 | AgNps in Relation to the Amount of Polymers (%) | Ibuprofen (mg) |
|---|---|---|---|---|---|
| C2P2.10 | 50/50 | 1/10 | 1/20 | - | - |
| C2P2.10.Ag1 | 50/50 | 1/10 | 1/20 | 1 | - |
| C2P2.10-IBF | 50/50 | 1/10 | 1/20 | - | 200 |
| C2P2.10.Ag1-IBF | 50/50 | 1/10 | 1/20 | 1 | 200 |
| C2P4.10 | 50/100 | 1/10 | 1/20 | - | - |
| C2P4.10.Ag1 | 50/100 | 1/10 | 1/20 | 1 | - |
| C2P4.10-IBF | 50/100 | 1/10 | 1/20 | - | 200 |
| C2P4.10.Ag1-IBF | 50/100 | 1/10 | 1/20 | 1 | 200 |
Publisher’s Note: MDPI stays neutral with regard to jurisdictional claims in published maps and institutional affiliations. |
© 2022 by the authors. Licensee MDPI, Basel, Switzerland. This article is an open access article distributed under the terms and conditions of the Creative Commons Attribution (CC BY) license (https://creativecommons.org/licenses/by/4.0/).
Share and Cite
Cadinoiu, A.N.; Rata, D.M.; Daraba, O.M.; Ichim, D.L.; Popescu, I.; Solcan, C.; Solcan, G. Silver Nanoparticles Biocomposite Films with Antimicrobial Activity: In Vitro and In Vivo Tests. Int. J. Mol. Sci. 2022, 23, 10671. https://doi.org/10.3390/ijms231810671
Cadinoiu AN, Rata DM, Daraba OM, Ichim DL, Popescu I, Solcan C, Solcan G. Silver Nanoparticles Biocomposite Films with Antimicrobial Activity: In Vitro and In Vivo Tests. International Journal of Molecular Sciences. 2022; 23(18):10671. https://doi.org/10.3390/ijms231810671
Chicago/Turabian StyleCadinoiu, Anca Niculina, Delia Mihaela Rata, Oana Maria Daraba, Daniela Luminita Ichim, Irina Popescu, Carmen Solcan, and Gheorghe Solcan. 2022. "Silver Nanoparticles Biocomposite Films with Antimicrobial Activity: In Vitro and In Vivo Tests" International Journal of Molecular Sciences 23, no. 18: 10671. https://doi.org/10.3390/ijms231810671
APA StyleCadinoiu, A. N., Rata, D. M., Daraba, O. M., Ichim, D. L., Popescu, I., Solcan, C., & Solcan, G. (2022). Silver Nanoparticles Biocomposite Films with Antimicrobial Activity: In Vitro and In Vivo Tests. International Journal of Molecular Sciences, 23(18), 10671. https://doi.org/10.3390/ijms231810671

